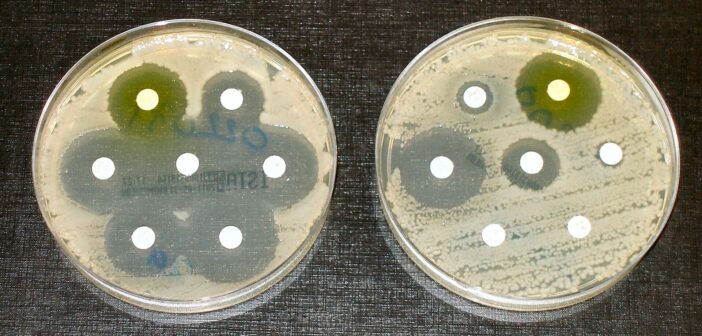

Antibiotikum rezisztencia gének (ARG-k) előfordulását és kifejeződési mintázatait vizsgálták a szegedi szennyvíztisztító üzemben a Szegedi Biológiai Kutatóközpont (HUN-REN SZBK) munkatársai – közölte a Magyar Kutatási Hálózathoz (HUN-REN) tartozó intézmény a honlapján.
A mikrobák antibiotikumokkal szembeni rezisztenciáját biztosító gének alapvetően ősi eredetűek, azonban az emberi tevékenység, például az antibiotikumok széles körű alkalmazása, szelekciós nyomást jelent, és hozzájárul a rezisztens mikrobák terjedéséhez. Ennek következtében az antibiotikumokkal szemben ellenálló kórokozók által jelentett kockázat folyamatosan növekszik.
A városi szennyvíztisztító telepek, amelyek az aktivált iszap és az anaerob lebontás kombinációját alkalmazzák, nemcsak a szennyvíz tisztítását szolgálják, hanem olyan eljárást is biztosítanak, amely csökkenti a kórokozó baktériumok mennyiségét, miközben fenntartható energiahordozót, biometánt termelnek. A szerves anyagok lebontása időigényes folyamat, és közben a mikrobaközösségekben a megbetegedést okozó és nem patogén populációk között antibiotikum-rezisztencia gének átadása is megtörténhet.
Az összetett mikrobiomokban élő mikrobák vizsgálatát nehezíti, hogy a legtöbb mikroba nem képes elkülönülten életben maradni, hanem komplex közösségi interakciókra támaszkodik. Ennek következtében az ARG-hordozók azonosítása speciális módszereket igényel.
A rangos Water Research folyóiratban ismertetett kutatás során Wirth Roland és munkatársai a Szeged városi szennyvíztisztító telep mintáiból rekonstruálták a mikrobák genomjait, azonosították az általuk hordozott ARG-ket, és vizsgálták azok kifejeződését a különböző kezelési szakaszok során. Vizsgálatuk során nemcsak az ARG-ek jelenlétét, hanem azok tényleges aktivitását és a klinikum számára potenciális kockázatát is felmérték.
Az eredmények szerint a szennyvíztisztításra jellemző mikrobiomok komplex, többféle forrásból származó mikroorganizmusból állnak. Az emberi megbetegedést okozó mikrobák aránya a szennyvízkezelés során jelentősen csökkent, míg a környezeti populációk száma nőtt, ami arra utal, hogy a szennyvízkezelés során kialakul egy sajátos mikrobiom, amely génbankként is funkcionálhat.
A tanulmány rámutat, hogy a szennyvíztisztítás – különösen az anaerob kezelés – hatékonyan csökkenti az emberi eredetű, potenciálisan patogén mikroba populációkat és a legmagasabb kockázatú ARG-ket, ugyanakkor egyes kulcsfontosságú rezisztencia gének – köztük egy széles spektrumú antibiotikum-csoporttal, a fluoroquinolonnal szemben rezisztenciát eredményező gének – továbbra is aktívak maradhatnak.
A szakemberek cikkükben hangsúlyozták, hogy a közegészségügyi kockázatok felméréséhez nem elegendő csupán a gének jelenlétét vizsgálni, hanem figyelembe kell venni azok kifejeződését, a mobilis genetikai elemek szerepét, valamint a patogén mikrobák jelenlétét és eredetét a szennyvíztisztító rendszerben.
Forrás: MTI